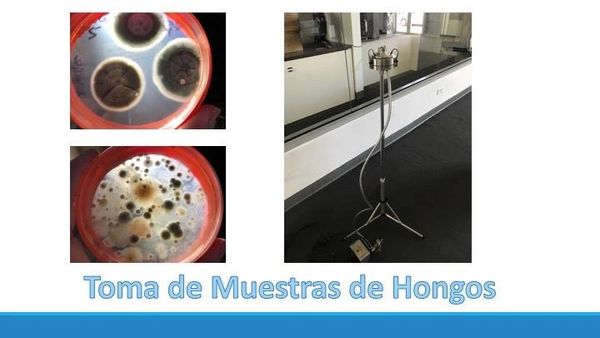

Inspecciones Gratis, sirviendo a todo Puerto Rico 787-787-0000. Control de hongos, aire contaminación y Calidad del Aire Puerto Rico
Profesionalismo y Experiencia
Comunícate con nosotros
Comunícate con nosotros
Action Enviromental Contractors
PO Box 9225, Bayamon, PR 00960
Video
Let's talk about Disinfectants
Know about EPA N list.
Cómo viajar en tiempos de COVID-19
Conoce las mejores prácticas para evitar el contagio.
¿Trabajas en un Edificio Enfermo?
Descubre cuales son las características de un Edificio Enfermo. Quizás tu estés pasando por este síndrome.
Tratamientos Desinfectantes contra el COVID-19.
Salvando vidas mediante tratamientos desinfectantes.
Nuestros socios
Controla el contagio del Covid-19
Los tratamientos desinfectantes son efica
Tratamientos de Higienización en contra del Covid-19
Si alguien en tu oficina es diagnosticado con Covid-19, se debe dar un tratamiento desinfectante a todas las superficies para evitar el contagio. En Action Environmental brindamos tratamientos desinfectantes para superficies eliminando los residuos del virus y haciendo el ambiente seguro para ti y tus empleados. Puedes regresar a trabajar en un ambiente desinfectado sin temor a contagiarte. Llama para consulta GRATIS +1-787-787-0000 sirviendo a todo Puerto Rico.
Especialistas en Calidad de Aire

Videos de Servicios
Conoce las mejores prácticas de prevención para el Corona Virus Covid-19 y cómo puedes desinfectar las superficies afectadas por alguna persona contagiada. Para consultas puedes llamar al 787-787-0000 para servicios en todo Puerto Rico.
Sirviendo a Puerto Rico, USVI y Florida

Ofrecemos Servicios de:
- Tratamientos de Higienización contra el Coronavirus
- Análisis de Calidad de Aire
- Limpieza de Ductos de Aire Acondicionado
- Balanceo de Unidades y Flujo de Aire
- Mantenimiento de Unidades de Aire
- Control de Hongos en Superficies
- Tratamientos Desinfectantes en el Aire
- Toma de Muestras de Hongos Ambientales
- Estimados para Seguros con Mapa de Humedad
- Limpieza de Colectores de Polvo
- Tratamientos para Edificios Enfermos
- Remediación de Inundaciones
- Control de Hongos en Libros, Maderas y Pieles
- Control de Plagas
- Servicios de Limpieza Industrial

Services:
- A/C Duct Cleaning
- Air Balancing
- HVAC Maintenance
- Mold Remediation in Surfaces
- Sanitizing Treatment in Air
- Mold Sampling with Genus and Species
- Water / Moisture Mapping
- Insurance Reports and Quotes
- Mold Remediation in Books, Woods and Leather
- Pest Control
- Industrial Janitorial Services

Services:
- A/C Duct Cleaning
- Air Balancing
- HVAC Maintenance
- Mold Remediation in Surfaces
- Sanitizing Treatment in Air
- Mold Sampling with Genus and Species
- Water / Moisture Mapping
- Insurance Reports and Quotes
- Mold Remediation in Books, Woods and Leather
- Pest Control
- Industrial Janitorial Services

A Woman-Owned Business
Lydia Boschetti, Ph.D, CMR, CMS/ President and CEO
AEC is a Woman Owned Business
Certified Women-Owned Small Business
Minority Small Disadvantage Business
Hispanic American Owned
Action Environmental Contractors
In Action Environmental Contractors we do a full inspection of the building, we evaluate which materials are recommended to change and what are those materials that can be remediated. After Action Environmental Contractor leaves this building the building becomes totally safe for all the personnel, both working and customers who can enter these facilities.
Call Us! 787-787-0000 Action Environmental Contractors, taking care of your environment!
Síndrome del Edificio Enfermo
El Síndrome del Edificio Enfermo es una serie de síntomas de salud que presentan los ocupantes de un edifico con pobre calidad de aire. Conócelo! Hay formas de sanar el edificio y por consiguiente, mejorar tu salud. Llama para inspección GRATIS al 787-787-0000.
Control de Hongos en Edificios
Aquí conocerás las consecuencias de una inundación en un edificio comercial. Los hongos ambientales se apoderaron de el interior de la estructura. Conoce cuáles son las consecuencias en la salud y cómo puede remediarse. Es posible recuperar la calidad de aire en el interior y regresar a la normalidad. Llama para inspección y estimado GRATIS 787-787-0000.
Control de Hongos en Ductos y Unidades de Aire
Aquí conocerás cómo controlar los hongos en los ductos de aire y en las unidades de aire acondicionado. Llama para estimado GRATIS al 787-787-0000 o visita nuestra página web www.7870000.com. Sirviendo en Puerto Rico, Islas Vírgenes y Florida.
Toma de Muestras de Hongos Ambientales
Aquí conocerás la importancia de tomar muestras de hongos ambientales en tu oficina. Saber qué tipo de hongo está afectando tu salud te permite conocer cómo remediarlo y cómo mejorar la calidad de aire en tu lugar de trabajo.
Copyright © 2021 Action Enviromental Contractors - Todos los derechos reservados.
Con tecnología de GoDaddy


